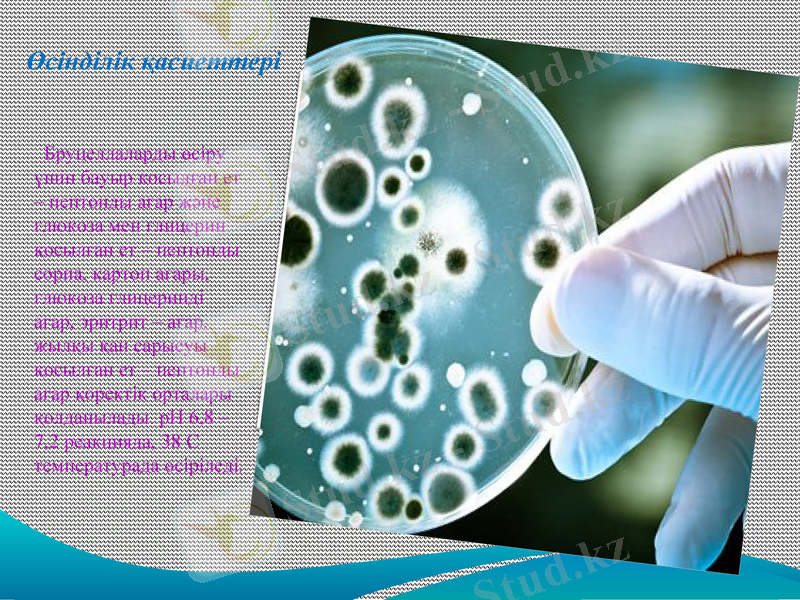
Slide 7
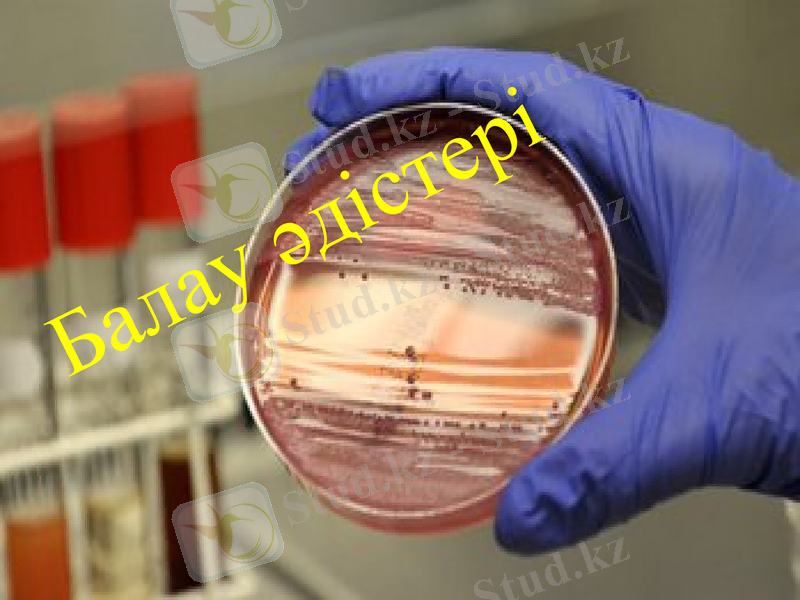
Slide 9

Бруцеллезді диагностикалау: бактериологиялық және серологиялық әдістері



ҚАЗАҚСТАН РЕСПУБЛИКАСЫ БІЛІМ ЖӘНЕ ҒЫЛЫМ МИНИСТРЛІГІ СЕМЕЙ ҚАЛАСЫНЫҢ ШӘКӘРІМ АТЫНДАҒЫ МЕМЛЕКЕТТІК УНИВЕРСИТЕТІ АГРАРЛЫҚ ФАКУЛЬТЕТ «ВЕТЕРИНАРИЯЛЫҚ САНИТАРИЯ» КАФЕДРАСЫ
Тақырыбы: Бруцеллезді балау әдістері
ОРЫНДАҒАН : Сырымова. Б. Е
ТЕКСЕРГЕН : Нуркенова. М. К
БӨЖ

Бруцеллез - үй және жабайы жануарлардың жұқпалы ауруы, ауру малдың дене қызуы көтеріледі, аяқтары мен буындары, нерв жүйесі зақымданады, іш тастайды, шуы түспейді, эндометрит, қысыр қалады.
Алғаш рет қоздырғышын 1886 жылы Брюс бөліп алған.


Бруцеллез ауруы кезіндегі жануар организміндегі өзгерістер

Берджидің жіктеуі бойынша Brucella тұқымының 6 түрі бар:

Өсінділік қасиеттері
Бруцеллаларды өсіру үшін бауыр қосылған ет - пептонды агар және глюкоза мен глицерин қосылған ет - пептонды сорпа, картоп агары, глюкоза глицеринді агар, эритрит - агар, жылқы қан сарысуы қосылған ет - пептонды агар қоректік орталары қолданылады. рН 6, 8 - 7, 2 реакцияда, 38 С температурада өсіріледі.

Балау әдістері


Бактериоскопиялық зерттеу. Зерттелінетін материал жағындысын Грам және Козловский әдісімен бояйды.
Козловский әдісі бойынша басқа микроорганизмдер көк түске, бруцелла қызыл түске боялады.
Бруцелла Грам әдісі бойынша қызыл түске боялады.

Серологиялық реакциялардан бруцеллез диагностикасын қоюға ең жиі қолданылатыны АР мен КБР.
Агглютинацияның пробиркалық реакциясын түбі біркелкі дөңес пробиркаларға төрт түрлі сұйытылған 1 мл мөлшерінде жасайды. Шошқа, кой, ешкі, бұғы, ит қан сарысулары 1:25, 1:50, 1:100, 1:200 қатынасында; сиыр, жылкы және түйе қан сарысулары 1:50, 1:100. 1:200, 1:400 катынасында сұйытылған түрінде алынады. Жаппай зерттеулерде АР-сын сұйытылған түрінде жасауға болады, бірақ бұлай еткенде, он нәтижс берген реакцияларды төрт сұйытылған түрінде кайта тексереді.

Шошка, кой, ешкі, бұгы жэне ит кан сарысуында 1:50 катынасында ал сиыр, жылкы, түйе үшін 1:100 және одан артық сұйытылған жағдайда агглютинация жүрсе реакция оң деп саналады. Шошка, кой, ешкі, бұғы және ит 1:25 катынасында және сиыр, жылқы, түйе 1:50 қатынасындан сұйытылған кан сарысуында ғана агглютинация реакциясы жүрсе күмәнді реакция болады. Күмәнді реакцияда жануардың кан сарысуын 3-4 аптадан кейін кайта зерттейді. Бруцеллез каупі бар фсрмадағы малдарды кайтадан зерттегенде күмәнді АР кайтадан кайталаған жағдайда реакция оң деп саналады.



Қолданылған әдебиеттер:
Иммунология. ., А. Қ. Бұлашев. Астана, 1998
Малдың жұқпалы ауруларын бактериологиялық балау. ., Кіркімбаева Ж. С., Орынтаев Қ. Б
Омарбеков Е. О. Вирусология пәнінің зертханалық сабақтары. Семей, 2001
Толысбаев Б. Т, Шоқанов Н, Булашев А, Бияшев Қ, Мал дәрігерлік микробиология. Алматы, 1999
5. Сайдулдин Т. С Ветеринариялық індеттану, 1-2 кітап. Алматы, 1999

Назарларыңызға рахмет!!!
- Іс жүргізу
- Автоматтандыру, Техника
- Алғашқы әскери дайындық
- Астрономия
- Ауыл шаруашылығы
- Банк ісі
- Бизнесті бағалау
- Биология
- Бухгалтерлік іс
- Валеология
- Ветеринария
- География
- Геология, Геофизика, Геодезия
- Дін
- Ет, сүт, шарап өнімдері
- Жалпы тарих
- Жер кадастрі, Жылжымайтын мүлік
- Журналистика
- Информатика
- Кеден ісі
- Маркетинг
- Математика, Геометрия
- Медицина
- Мемлекеттік басқару
- Менеджмент
- Мұнай, Газ
- Мұрағат ісі
- Мәдениеттану
- ОБЖ (Основы безопасности жизнедеятельности)
- Педагогика
- Полиграфия
- Психология
- Салық
- Саясаттану
- Сақтандыру
- Сертификаттау, стандарттау
- Социология, Демография
- Спорт
- Статистика
- Тілтану, Филология
- Тарихи тұлғалар
- Тау-кен ісі
- Транспорт
- Туризм
- Физика
- Философия
- Халықаралық қатынастар
- Химия
- Экология, Қоршаған ортаны қорғау
- Экономика
- Экономикалық география
- Электротехника
- Қазақстан тарихы
- Қаржы
- Құрылыс
- Құқық, Криминалистика
- Әдебиет
- Өнер, музыка
- Өнеркәсіп, Өндіріс
Қазақ тілінде жазылған рефераттар, курстық жұмыстар, дипломдық жұмыстар бойынша біздің қор #1 болып табылады.



Ақпарат
Қосымша
Email: info@stud.kz